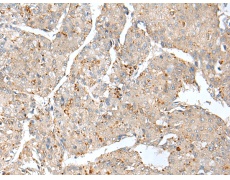
一抗

|
Background: |
THEM5 (thioesterase superfamily member 5) is a 247 amino acid protein that belongs to the thioesterase superfamily. The gene that encodes THEM5 contains nearly 8,000 bases and maps to human chromosome 1q21.3. Chromosome 1 is the largest human chromosome spanning about 260 million base pairs and making up 8% of the human genome. There are about 3,000 genes on chromosome 1, and considering the great number of genes there are also a large number of diseases associated with chromosome 1. Notably, the rare aging disease Hutchinson-Gilford progeria is associated with the LMNA gene which encodes lamin A. When defective, the LMNA gene product can build up in the nucleus and cause characteristic nuclear blebs. The mechanism of rapidly enhanced aging is unclear and is a topic of continuing exploration. The MUTYH gene is located on chromosome 1 and is partially responsible for familial adenomatous polyposis. Stickler syndrome, Parkinsons, Gaucher disease and Usher syndrome are also associated with chromosome 1. Has acyl-CoA thioesterase activity towards long-chain (C16 and C18) fatty acyl-CoA substrates, with a preference for linoleyl-CoA and other unsaturated long-chain fatty acid-CoA esters. Plays an important role in mitochondrial fatty acid metabolism, and in remodeling of the mitochondrial lipid cardiolipin. Required for normal mitochondrial function. |
|
Applications: |
ELISA, IHC |
|
Name of antibody: |
THEM5 |
|
Immunogen: |
Full length fusion protein |
|
Full name: |
thioesterase superfamily member 5 |
|
Synonyms: |
ACOT15 |
|
SwissProt: |
Q8N1Q8 |
|
ELISA Recommended dilution: |
5000-10000 |
|
IHC positive control: |
Human liver cancer |
|
IHC Recommend dilution: |
25-100 |

 購物車
購物車 幫助
幫助
 021-54845833/15800441009
021-54845833/15800441009